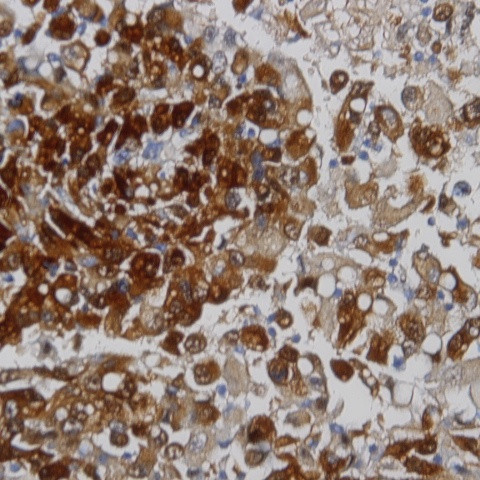
Melanosome Antibody in Immunohistochemistry (Paraffin) (IHC (P))

Search
AbboMax
Melanosome Monoclonal Antibody (HMB45)
{{$productOrderCtrl.translations['antibody.pdp.commerceCard.promotion.promotions']}}
{{$productOrderCtrl.translations['antibody.pdp.commerceCard.promotion.viewpromo']}}
{{$productOrderCtrl.translations['antibody.pdp.commerceCard.promotion.promocode']}}: {{promo.promoCode}} {{promo.promoTitle}} {{promo.promoDescription}}. {{$productOrderCtrl.translations['antibody.pdp.commerceCard.promotion.learnmore']}}
图: 1 / 1
Melanosome Antibody (603-840) in IHC (P)

产品信息
603-840
种属反应
宿主/亚型
分类
类型
克隆号
抗原
偶联物
形式
浓度
纯化类型
保存液
内含物
保存条件
运输条件
产品详细信息
Positive control: Melanoma
Cellular location: melanosome.
靶标信息
Melanoma is a malignant tumor of melanocytes which are found predominantly in skin but also in the bowel and the eye (see uveal melanoma). It is one of the rarer types of skin cancer but causes the majority of skin cancer related deaths.
仅用于科研。不用于诊断过程。未经明确授权不得转售。
篇参考文献 (0)
生物信息学
蛋白别名: 95kDa melanocyte-specific secreted glycoprotein; ME20-M; ME20M; Melanocyte lineage specific antigen GP100; melanocyte protein mel 17; Melanocyte protein PMEL; Melanocyte protein Pmel 17; Melanocytes lineage-specific antigen GP100; Melanoma-associated ME20 antigen; melanosomal matrix protein17; P1; P100; Pmel 17; Premelanosome protein; Silver locus protein homolog; silver, mouse, homolog of
基因别名: D12S53E; gp100; ME20; ME20-M; ME20M; P1; P100; PMEL; PMEL17; SI; SIL; SILV
UniProt ID: (Human) P40967
Entrez Gene ID: (Human) 6490